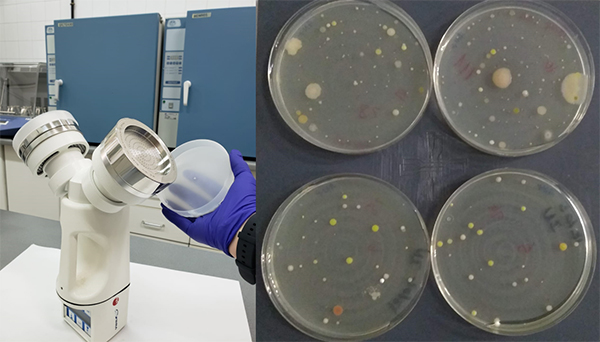
hospital

¿Qué encontramos en el aire de un hospital?
Investigadores de la UPM han participado en un estudio sobre la presencia de microorganismos en el aire de un hospital de Madrid y sus alrededores para evaluar su impacto sobre la salud.
12.06.23
Un trabajo reciente llevado a cabo por investigadores de la Universidad Politécnica de Madrid (UPM) ha abordado el estudio de la calidad del aire en el Hospital Clínico San Carlos en el marco de una investigación financiada por el Programa AIRTEC-CM de la Comunidad de Madrid. Durante varias semanas, tanto en invierno como en verano, se recolectaron numerosas muestras de aire del interior de una habitación del hospital y de zonas del exterior para estudiar la presencia de bacterias y de hongos empleando técnicas basadas en el análisis del material genético (ADN). Al comparar las muestras de aire del interior y del exterior del hospital se observó que la mayor parte de las bacterias y hongos detectados en la habitación del hospital también estaban presentes en el aire exterior lo que indicaría que su procedencia es mayoritariamente ambiental. Además, una de las conclusiones más relevantes del estudio ha sido constatar que el ambiente hospitalario no actúa como un punto de emisión de patógenos relevante hacia la ciudad. En el trabajo también han colaborado investigadores de la Universidad Complutense de Madrid, del CIEMAT-CSIC y del Instituto de Investigación Sanitaria Hospital Clínico San Carlos (IdISSC).
Muestreador de aire utilizado en la investigación (izq.) y placas de cultivo con algunas bacterias aisladas del aire (drcha). (Fuente: AIRTEC-CM)
Los hospitales son centros de referencia para la atención y cuidado de enfermos a los que acuden diariamente cientos de personas, no solo a sus citas médicas o urgencias, sino también a visitar a pacientes ingresados y a trabajar. Muchas de las patologías que se consultan y tratan en estos centros son causadas por agentes infecciosos como bacterias, hongos y virus que, debido a su tamaño microscópico, pueden diseminarse fácilmente por el aire y ser inhalados durante la respiración. Por ello, también se plantea la duda de si los hospitales pueden actuar como puntos de emisión de estos microbios al resto de la ciudad y las consecuencias perjudiciales sobre la salud que ello ocasionaría.
Un estudio llevado a cabo por investigadores de la Escuela Técnica Superior de Ingenieros industriales (ETSII) de la UPM, ha abordado esta y otras cuestiones en el Hospital Clínico San Carlos de Madrid, en el marco de una investigación financiada por la Comunidad de Madrid (Programa AIRTEC-CM). En concreto, los investigadores recolectaron numerosas muestras de aire del interior de una habitación del hospital y de zonas del exterior a lo largo de dos campañas de muestreo que duraron varias semanas en verano de 2020 e invierno de 2021. En estas muestras se estudió la presencia de bacterias y de hongos empleando técnicas basadas en el análisis del material genético (ADN). Todos los seres vivos, incluidos los microorganismos, poseen una región característica en su ADN que permite distinguir unos de otros, lo que hace posible identificar la biodiversidad existente (microorganismos distintos) y estimar su abundancia relativa. Al comparar las muestras de aire del interior y del exterior del hospital se comprobó que la mayor parte de las bacterias y hongos detectados en la habitación del hospital (que se mantuvo cerrada y sin actividad humana) también estaban presentes en el aire exterior. Las variaciones estacionales en composición y abundancia relativa que experimentan los microorganismos en el exterior se observaron también en el interior. Esto indicaría que su procedencia es mayoritariamente ambiental y que los microorganismos logran infiltrarse en el interior del edificio a través de los resquicios de puertas y ventanas impulsados por el viento, algo frecuente en todo tipo de edificios incluyendo nuestras casas.
Otro hallazgo interesante fue identificar un grupo de bacterias que típicamente se encuentran asociadas a la piel del ser humano en las muestras de aire. Los niveles de estas bacterias fueron siempre mayores en la habitación del hospital, lo que indicaría que la actividad que se realiza en el interior de los edificios deja una huella particular, influenciando los microorganismos que podemos encontrar allí.
Una de las cuestiones más importantes fue desvelar si en el hospital se acumulaban microorganismos patógenos y si estos se podían diseminar hacia el exterior. Los investigadores detectaron bajos niveles de microorganismos potencialmente peligrosos en el interior del edificio, pero también en el exterior y en zonas alejadas de la posible influencia del hospital. En numerosos estudios realizados en ambientes urbanos de todo el mundo también se ha detectado cierto nivel de microbios potencialmente patógenos en el aire de las ciudades independientemente de la presencia de hospitales cercanos.
Según declara Ana M García, investigadora responsable del grupo BIO-MAT de la UPM: “Los resultados que hemos obtenido sugieren que este ambiente hospitalario no actúa como un punto de emisión de patógenos relevante en la ciudad.” Además, los investigadores aclaran que las técnicas de estudio basadas en el ADN no permiten distinguir si estos patógenos son viables (con capacidad para provocar enfermedades) o no, lo que todavía reduciría aún más el posible riesgo sobre la salud.

Miembros del consorcio AIRTEC-CM en la azotea del Hospital Clínico San Carlos. (Fuente: AIRTEC-CM)
Adicionalmente, los investigadores analizaron si abrir la ventana de la habitación tenía algún impacto sobre los microorganismos del interior. Sus resultados indican que después de dos horas con la ventana abierta no se producen cambios significativos. Junto a resultados similares de otros estudios previos, los autores matizan que, para lograr una buena ventilación en cuestión de hongos y bacterias, abrir las ventanas debería acompañarse de la apertura de puertas u otros sistemas activos como ventiladores para crear corrientes que movilicen este tipo concreto de partículas.
Andrés Núñez, Ana M. García. The aerobiome in a hospital environment: Characterization, seasonal tendencies and the effect of window opening ventilation. Building and Environment 230 (2023) https://doi.org/10.1016/j.buildenv.2023.110024
